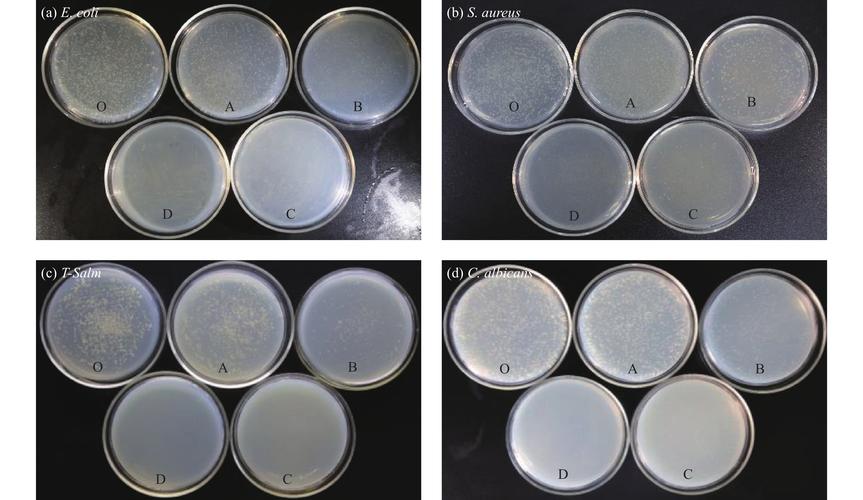
量子点与ULED，哪种显示技术更优？-图2

量子点技术与ULED技术作为当前显示领域的前沿解决方案,分别以独特的光学特性与硬件架构革新,推动着显示性能向更高维度突破,两者在色彩表现、亮度控制、对比度优化等核心指标上各有侧重,却又通过技术融合不断拓展显示体验的边界。

量子点技术的核心原理与优势
量子点技术是一种基于纳米半导体材料的发光技术,其核心在于通过调控量子点的尺寸(通常2-10纳米)来精确激发不同波长的光,当量子点受到蓝光或紫外光激发时,会产生量子限域效应,尺寸较小的量子点发出蓝绿光,尺寸较大的则发出红光,从而实现高纯度的红、绿、蓝三基色,这一特性使其在色彩表现上具备天然优势:色域覆盖范围可达BT.2025标准的90%以上,色纯度较传统LCD提升约50%,且色彩稳定性强,不会因长时间使用而发生衰减。
在显示应用中,量子点技术主要分为两种路径:其一为量子点膜(QDEF),将量子点材料制成薄膜,置于LED背光与液晶层之间,通过蓝光LED激发量子点产生广色域背光;其二为量子点LED(QLED),直接将量子点作为发光层,结合OLED的主动发光原理实现自发光显示,前者成本较低,兼容现有LCD产线,后者则响应速度更快、功耗更低,但技术难度与成本更高,量子点技术还可通过优化光路设计,提升背光均匀性,减少漏光现象,进一步改善画质。
ULED技术的硬件架构与创新
ULED(Ultra-LED)是由中国厂商自主研发的显示技术,其核心在于通过“多分区独立控光”与“纳米级光学调控”实现极致画质,与传统LCD相比,ULED摒弃了单一的背光层,转而采用数百至数千个Mini LED背光分区,每个分区可独立开关亮度,结合动态对比度技术,使黑色表现更深邃(对比度可达100000:1以上),同时有效抑制光晕,提升暗场细节。
在色彩与亮度层面,ULED通过“量子点色彩增强层”与“广色域LED背光”的协同,实现色域覆盖与量子点技术相当,且峰值亮度可达2000尼特以上,支持HDR10+、杜比视界等高动态范围格式,ULED还引入了“16bits级精细控光”技术,通过算法对每个背光分区的亮度进行4096级调节,使画面明暗过渡更自然,硬件上,ULED采用金属框架散热结构,解决高亮度下的散热问题,并通过AI画质芯片实时优化动态画面,减少拖影与模糊。
两种技术的对比与融合方向
量子点技术与ULED技术并非替代关系,而是在不同维度上互补,量子点技术侧重色彩纯度与光效优化,ULED则聚焦硬件层面的控光精度与对比度突破,从性能对比来看,两者在色域覆盖上接近,但ULED在对比度、亮度均匀性及动态响应速度上更具优势,而量子点技术在成本控制与成熟度上占优。
当前,行业已出现技术融合趋势:部分高端ULED产品直接集成量子点色彩增强层,既通过多分区控光实现高对比度,又借助量子点提升色彩表现,形成“量子点+多分区控光”的复合架构,某些旗舰机型采用5000+分区Mini LED背光,配合量子点膜,色域覆盖达115% DCI-P3,对比度突破1000000:1,同时支持240Hz刷新率,兼顾游戏与影视需求,量子点技术与OLED的融合也正在探索,如量子点OLED(QD-OLED)结合了量子点的色彩优势与OLED的自发光特性,成为下一代显示技术的潜力方向。
相关问答FAQs
Q1:量子点技术与OLED相比,在寿命和功耗上有何差异?
A1:量子点技术的寿命主要取决于背光光源(如LED)的稳定性,通常可达50000小时以上,而OLED因有机材料老化,寿命约30000小时,功耗方面,量子点LCD的功耗与普通LCD接近,低于OLED;但QLED自发光版本的功耗与OLED相当,且在低亮度场景下更节能。
Q2:ULED技术的多分区控光是否会导致画面分割感?
A2:现代ULED技术通过AI算法优化分区亮度过渡,结合“动态融合控光”技术,可大幅减少分区边界的光线突变,当画面中出现渐变天空或人物轮廓时,系统会自动调整相邻分区的亮度差异,使过渡自然,肉眼几乎无法察觉分区痕迹,仅在极端高对比度场景下(如纯黑与纯白相邻)可能出现轻微分割感,但实际观看中影响极小。

